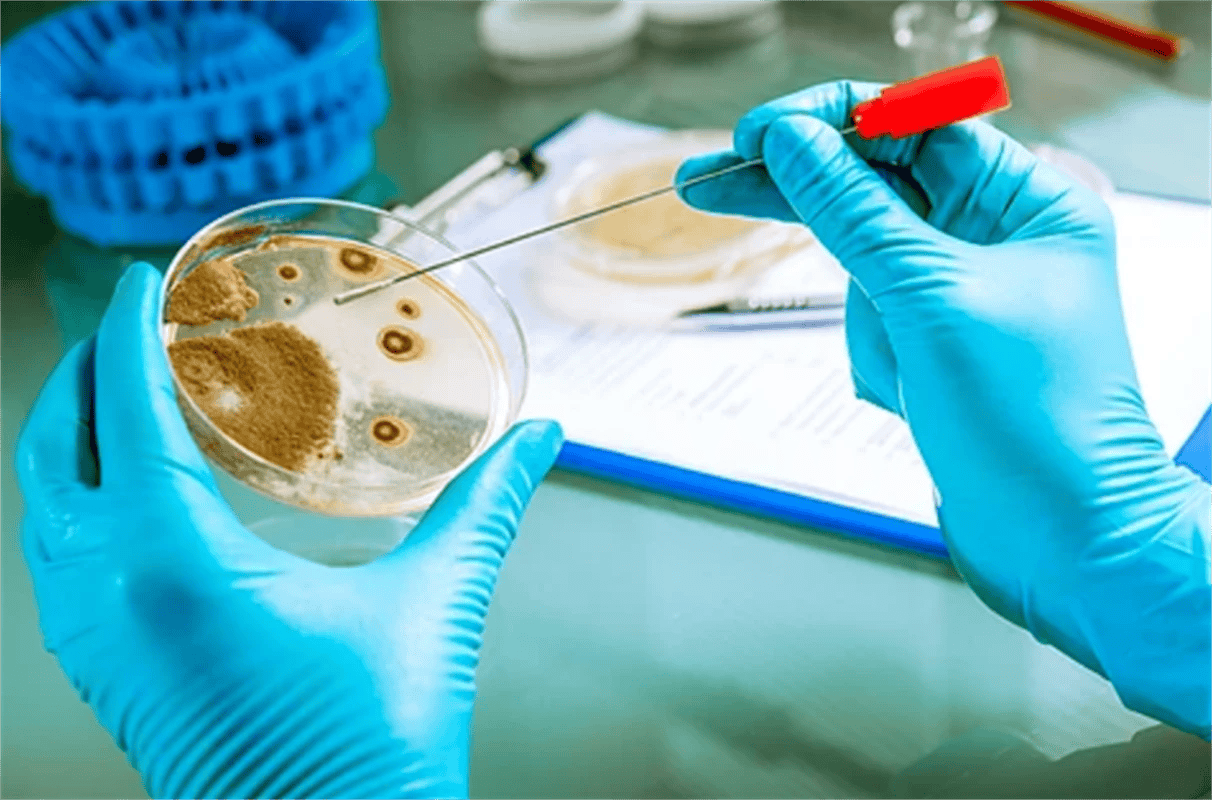

5YR企业会员
发布人:西安凯新生物科技有限公司
发布日期:2025/11/21 9:26:04
关键词:DSPE-hyd-MPEG,Phospholipids-hyd-MPEG
产品介绍:
DSPE-hyd-MPEG通常呈白色或类白色至浅黄色半固体或固体,外观取决于MPEG的分子量。由于DSPE和MPEG都是具有良好生物相容性的物质,DSPE-hyd-MPEG也表现出优异的生物相容性,不会引起免疫反应。
二硬脂酰基磷脂酰乙醇胺,是一种磷脂成分,为DSPE-hyd-MPEG提供了脂质体的结构稳定性,并嵌入脂质体双层中。甲氧基聚乙二醇,是一种亲水性聚合物。MPEG的引入为DSPE-hyd-MPEG提供了一个“隐形”屏障,能够防止蛋白质吸附和巨噬细胞吞噬,从而延长其在体内的循环时间。
相关参数:
中文名称:二硬脂酰基磷脂酰乙醇胺-腙键-甲氧基聚乙二醇
英文名称:DSPE-hyd-MPEG,Phospholipids-hyd-MPEG
分子量:0.4k,0.6k,0.8k,1k,2k,5k,10k,20k,50k(可按需定制)
外观:固体/粉末
纯度:95%,详情可在线咨询
发货:订单截止时间为每日16点整,部分城市可到17点整。
注意事项:在有粉尘生成的地方,提供合适的排风设备。不要让产物进入下水道。本品仅供科研用途,不作为其它用途。
保存建议: 需要存储在-20°C,避光,避湿的环境。取用一定要干燥,避免反复冻融。

同类型相关试剂:
BODIPY 558/568 carboxylic acid
BODIPY 558/568 羧酸
Cyanine2 NHS Ester
186205-33-4
Cy2活性酯
BODIPY TMR carboxylic acid
BODIPY FL amine
BODIPY FL NH2
Pyrenebutyric acid
Pyrenebutyric COOH
Cyanine2 amine
Cy2 NH2
Cyanine2氨基
上述信息均由西安凯新生物科技的小编小兮所整理
相关新闻资讯